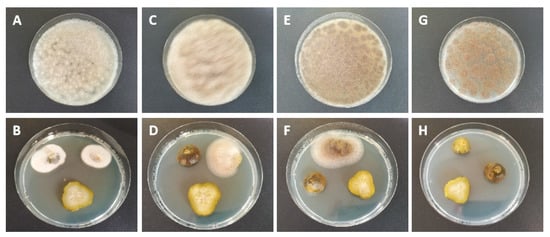

Abstract
Fungi and their enzymes have long been thought to cause the softening of pasteurized gherkins; however, the exact fungal species and timing of contamination are unknown. Ready-to-sell pickle jars and blossoms of growing gherkins were inoculated with DNA-sequenced fungi isolated from rotting gherkins to cause softening at various stages of production. Ready-to-sell gherkins inoculated with Fusarium oxysporum, Fusarium equiseti, Galactomyces geotrichum, Mucor circinelloides, Mucor hiemalis, Mucor fragilis, Plectosphaerella cucumerina, Alternaria sp., and Cladosporium sp. indicated a measurable texture reduction after pasteurization and 6 months of storage at room temperature. No texture changes were observed in gherkins infected during the growth phase. The fungi M. hiemalis, M. fragilis, and G. geotrichum tolerated the acidic-saline (approx. pH 4) environment in the jar for several days, thus the pectinolytic enzymes of these candidates were tested for heat and pH resistance. Although the measured endo-Polygalacturonase (PG) of M. fragilis had its optimum activity at pH < 4, all fungal enzymes were inactivated within 3 min at 80 °C corresponding to the pasteurization heat. Our study shows that conventionally occurring fungi and their enzymes have the potential to induce softening in pickles. Softening by these fungi is unlikely due to post- or pre-harvest contamination without any other influences.
1. Introduction
Quality characteristics of vegetables and fruits are defined by taste and appearance and significantly by sensory properties [1,2,3]. These properties can be influenced by production and post-harvest stress, processing steps, microbial contaminations, or pectinolytic enzymes [4,5]. The softening of pasteurized gherkins is an unexplained phenomenon that fails to meet customer expectations for a crunchy and firm texture and, consequently, can lead to complaints, a loss of brand image, and economic losses for producers [6]. Therefore, small, regional brands such as Spreewald gherkins (PGI) from Eastern Germany face global competition and depend on consistently high product quality. Cucumbers (Cucumis sativus) originating in Asia are one of the most widely cultivated cucurbits in the world [7,8]. Gherkins, or pickles, sold in commercial pickle mixtures are usually small, immature fruits of the common cucumber and a member of the Cucurbitaceae family. Gherkins can be eaten raw, but traditionally they are processed into pasteurized pickles in vinegar broth or fermented [1,2,9].
Specifically, softening in gherkins occurs when texture-stabilizing elements such as pectin and cellulose or cell wall elasticity and turgor are affected. The reason for this may be the physical or chemical origin, enzymatic digestion, or, more often, microbial activity during or after production and processing [10,11]. Hydrolysis of pectin (complex polysaccharides high in galacturonic acid) in the middle lamella of gherkins makes the fruit tissue unstable and soft. Polygalacturonases (endo-/exo-PG), pectin lyases, and pectinesterases (PE) are primarily responsible for pectin degradation [12,13,14].
Processing gherkins through pasteurization and vinegar broth is intended to ensure shelf life by inhibiting microbial growth and enzyme activity while causing minimal damage to texture and preserving the crunchiness and firmness of the gherkins. The environment of pickles alone is hostile to many microorganisms. However, some types of spoilage microorganisms such as heterofermentative lactic acid bacteria, yeasts, and molds have evolved physiological systems that allow them to tolerate the acetic acid concentrations, salt, and low pH in the products to survive under these highly inhibitory conditions. Therefore, previous research on the softening of gherkins investigated process parameters such as the heat treatment, salt content, vinegar variants, and pH value of the pickle broth or texture-stabilizing additives such as calcium for crosslinking of pectin to stabilize the product texture and minimize and inhibit microbial contamination [15,16,17,18,19]. The possible microbiological candidates contributing to gherkin softening are also the subject of science. Kersten et al. (2021) showed that a Zucchini yellow mosaic virus infection of cucumber plants and fruits was associated with the softening of pasteurized gherkins, which continued to lose firmness as storage progressed [20]. Etchells et al. (1958) and Raymond et al. (1959) demonstrated an increased abundance of fungi on cucumber blossoms [21,22]. The blossoms often adhere to the fruit and enter processing, potentially transferring fungal contaminants into the fermented product. Increased pectinolytic enzyme activity was additionally detected on the blossoms. Although the causative specific pathogen has not yet been determined, the detected species of the primarily identified genera are considered important sources of pectinolytic and cellulolytic enzymes [21,22]. On the other hand, studies on the specific softening of pasteurized gherkins did not detect any living microorganisms after pasteurization [23,24]. However, it is assumed that the residual enzyme activity of thermophilic fungi combined with stress or other damage to gherkins during post-harvest treatment leads to the progressive softening of the product [23]. In addition, low levels of native PG activity were detected in raw, immature cucumbers used for cucumber processing. It has been reported that a sufficient amount of native pectinolytic enzyme activity is retained despite heating and could cause softening of the cucumbers during storage [24,25,26]. However, clear evidence on the origin of the enzymes has not been provided to date. In particular, the heat and acid stability of the enzymes is decisive for their activity in the pickle jar after pasteurization and following product storage. Accordingly, the origin, residual type, and quantity of the enzymes in the pickle jar are decisive [24,25,26].
The objective of the present study was to initiate the softening of pasteurized gherkins by induced contamination with fungi isolated from rotting field-grown gherkins in order to identify the fungal causative agents for the softening of pickles. One focus of the study was to investigate the storage stability of the fungi used and their enzymes and the heat stability of these enzymes. The other main objective was to determine whether fungal contaminations cause softening of the final product at the time of gherkin growth or whether it affects the texture of the processed gherkins later in the production process.
2. Materials and Methods
2.1. Isolation of Various Fungi from Rotting Gherkins and DNA Extraction
Fresh gherkins originated from outdoor cultivation grown in the Spreewald region in Eastern Germany and were stored for ten days at room temperature in sterile plastic bags until the first signs of rot were visible on the surface of the gherkins. Samples were taken from five different rotting spots of the gherkins and plated as a dilution smear on Potato Dextrose Agar (PDA; Carl Roth, Karlsruhe, Germany) with 0.4 mg mL–1 chloramphenicol (Carl Roth, Karlsruhe, Germany). The inoculated plates were incubated at 25 °C for four days. Afterward, 44 separated and visually distinct fungal colonies from the dilution smears were transferred to PDA to prepare pure cultures. DNA was extracted from each of the pure fungal isolates using the NucleoSpin® Soil Kit (Macherey-Nagel GmbH and Co. KG, Düren, Germany; User’s Manual May 2016, Rev. 06) according to the manufacturer’s instructions after an incubation period of seven days. Therefore, biomass was partly harvested from the culture plates and treated with FastPrep®-24 (M.P. Biomedicals, Santa Ana, CA, USA) at 5 m/s for 30 s for mechanical lysis.
2.2. Sequencing
The extracted DNA of the pure fungal isolates originating from rotten gherkins was used for Sanger sequencing by LGC Genomics GmbH, Berlin, Germany. PCR amplification was performed with the standard primers ITS1F (5′-CTTGGTCATTTAGAGGAAGTAA-3′) and ITS4 (5′-TCCTCCGCTTATTGATATGC-3′). A PCR reaction of 50 µL volume contained 25 µL of PCR Master Mix (2×) (ThermoFisher Scientific, Waltham, MA, USA), 300 nM of each primer, and 1 µL of extracted DNA. The reaction was performed under the following conditions: 95 °C for 2 min; 10 cycles of 95 °C for 30 s and 60 °C for 30 s touch down 1 °C per cycle, followed by 72 °C for 1 min; 30 cycles of 95 °C for 30 s, 50 °C for 30 s and 72 °C for 1 min; finished by 72 °C for 8 min. The MSB Spin PCRapace Kit (Invitrogen AG, Waltham, MA, USA) was used for DNA purification according to the manufacturer’s instructions. Finally, DNA quality and quantity were confirmed using NanoDrop ND-1000 (Kisker Biotech GmbH and Co. KG, Steinfurt, Germany) and running a 1.5% agarose gel (1 kb DNA ladder). Sequencing was performed with the primers ITS1F and ITS4. The sequences obtained were edited with Chromas (free Version 2.6.6; Technelysium Pty Ltd., South Brisbane, QLD, AUS) and SeqMan II (Version 5.08; DNAStar Inc., Madison, WI, USA). These sequences were compared with sequences available in GenBank (“http://www.ncbi.nlm.nih.gov/”, accessed on 21 June 2021) using the Basic Local Alignment Search Tool for Nucleotides (BLASTN) on the NCBI website and UNITE (“https://unite.ut.ee/”, accessed on 21 June 2021; Abarenkov et al. (2010) [27]). The criteria for assigning a fungal isolate to a species were ≥99% homology combined with a minimum distance to the next best species of 0.8% [28]. All sequences are listed in the Supplementary Materials S1.
2.3. Preparation of Spore Suspension and Inoculation
The sequenced fungal cultures were used to prepare spore suspensions for the inoculation of ready-to-sell pickle jars and open gherkin blossoms in the greenhouse to induce the softening of the gherkins. A sufficient amount of fungal inoculants was obtained by transferring sections of the sequenced fungal material (fungal stock culture grown on PDA) to Synthetic Nutrient Agar (SNA) [29] for Fusarium and PDA for all other fungi. These fungal cultures were incubated in the dark at 25 °C for four days. Further cultivation was followed under mixed black light (near UV, emission 310–360 nm) and artificial daylight with a photoperiod of 12 h light: 12 h dark for three days. The fungal spore suspension was prepared by washing the culture surface with 1/4-strength Ringer’s solution. Coarse components of the obtained solutions were filtered off by a two-layered mull. The spore concentrations of the inoculants were counted with a Thoma counting chamber of 0.1 mm depth (Poly-Optik GmbH, Bad Blankenburg, Germany).
2.3.1. Inoculation of Ready-to-Sell Pickle Jars
Each prepared spore suspension was sterilely added to ready-to-sell pickle jars (with a 720 mL total volume with 310 mL of liquid and 360 mL of draining volume) produced in the Spreewald region. The ready-to-sell jars were pasteurized with all ingredients on an industrial scale and would have been suitable for retail. Spore suspensions were added in the appropriate amount to achieve a target concentration of 200 spores/mL or 2000 spores/mL in the jars. Three jars each were treated with suspensions of one fungus each of the species Fusarium oxysporum, Galactomyces geotrichum, Mucor circinelloides, Mucor fragilis, Mucor hiemalis, and the unspecified fungi of the genera Alternaria sp. and Cladosporium sp. No spore suspension could be obtained from the fungi Fusarium equiseti and Plectosphaerella cucumerina, therefore the inoculation of the jars was conducted with a 1 cm × 1 cm section of nutrient medium overgrown with mycelium. Table 1 shows an overview of inoculation schemes. Batch uniformity was ensured for the pickle jars used per inoculum and unopened pickle jars used as controls. The inoculated jars and controls, except for one jar per inoculation variant (low fungal concentration) and controls, were pasteurized on an industrial scale after seven days of incubation at 25 °C (re-pasteurized). Afterward, the re-pasteurized jars were stored for six months at room temperature until texture measurements. The ready-to-sell pickle jars were produced six months before inoculation and re-pasteurization. Therefore, the total storage time of all jars was 12 months. The influence of re-pasteurization was analyzed by storing additional control jars of the same batch without re-pasteurization under the same conditions for 12 months until textural measurement. The inoculated, not re-pasteurized jars were stored at 25 °C until further microbiological analysis after 14, 28, 70, and 180 days.

Table 1.
Number of ready-to-sell pickle jars inoculated with different fungal spore suspensions with different target spore concentrations in the jars.
2.3.2. Inoculation of Open Gherkin Blossoms in the Greenhouse
Fully opened gherkin blossoms grown in the greenhouse were inoculated once with a fungal inoculum (preparation as described above) at a spore concentration of 1 × 105 spores/mL. The inoculation of the blossoms was conducted at regular intervals of two to three days, starting eight weeks after sowing for three weeks. The inoculum was applied by using a spray bottle. Each blossom was treated with a 0.1 mL suspension of M. hiemalis, M. fragilis, G. geotrichum, or the mixed solution of all three fungi (each 1 × 105 spores/mL). During treatment, the blossoms were shielded to protect the environment and given 1 min of draining and drying time. The spore suspensions were always prepared fresh before application. Several pieces of fresh gherkins per inoculation variant, divided into the stem, center, and blossom parts, were placed on PDA, together with the blossom itself if present. This was performed to detect successful inoculation of the fruit. Fungal growth was documented after five days of incubation. The fungi were determined morphologically.
2.4. Greenhouse Experiment Design
C. sativus plants (F1 hybrids) of the cultivar ‘Platina’ (Nunhems Germany GmbH, Marbach, Germany) were grown in 10 L soil pots (Substrat 1, Klasmann-Deilmann GmbH, Geeste, Germany) under greenhouse conditions. Universal fertilizer WUXAL® (Wilhelm Haug GmbH & Co. KG, Düsseldorf, Germany) was applied weekly starting with the 6th week after sowing (100 mL of 1:1000 Fertilizer–water solution). Plant irrigation was performed by drip irrigation and was adjusted to the plant growth and climate. Blossoms of eight cucumber plants were inoculated with one of the three fungi M. hiemalis, M. fragilis, or G. geotrichum by spraying the spore suspension (see Section 2.3.2). Blossoms of four plants were inoculated with a mixed spore solution of all three fungi. Eight additional untreated plants served as controls. Plants with the same treatment were grown side by side and spaced apart from plants with different treatments and control. The experimental design is shown in Figure 1. Phenotypic characteristics of all plants were visually assessed each week to record the size (up to week 5 after sowing), yield, and presence of disease symptoms on leaves, flowers, and fruits.

Figure 1.
Cultivation design of Cucumis sativus plants grown in the greenhouse. Fully opened blossoms of eight gherkin plants were inoculated with one of the three fungi Mucor hiemalis, Mucor fragilis, or Galactomyces geotrichum by spraying spore suspension obtained from nutrient plates. Blossoms of four plants were inoculated with a mixed spore suspension of all three fungi. Eight plants served as untreated control. Plants with the same treatment were grown side by side and spaced apart from plants with different treatments and control.
2.5. Harvesting and Pasteurization of Inoculated Greenhouse Cucumbers
Fruits with a length of 6 to 9 cm were harvested approximately 12 days after the inoculation of the cucumber blossoms with the spore suspension. The length of the harvested fruits corresponds to the most commonly used size for industrial preservation. The fruits were processed directly after harvest. The gherkins were pasteurized along with the attached blossom residues (if present) to simulate a possible introduction of fungal contaminants into the jar through the blossoms. All fruits were pasteurized separately in 150 mL jars filled with commercial gherkin vinegar solution. The fruits were completely covered by the vinegar solution. Pasteurization was performed with a water-filled automatic preserving cooker for 32 min with a target temperature of 82 °C, starting at a water temperature of 35 °C. Three-quarters of the jars were covered with water. Finally, the jars were cooled down in a water bath of 30 °C and stored at room temperature for three months until texture measurement.
2.6. Texture Measurement
Texture quality is based on the measurement of crunchiness and firmness. The texture of fresh cucumbers grown from inoculated blossoms in the greenhouse was measured within 48 h after harvest. All pasteurized pickles grown from inoculated blossoms in the greenhouse were stored for three months until texture measurement. Textures of pickles from re-pasteurized, ready-to-sell pickle jars were measured six months after re-pasteurization, meaning 12 months after production. In total, seven gherkins of a ready-to-sell jar were always selected for texture measurement.
A 1 cm thick cross-sectional slice was all along cut from the middle of the gherkin using a 1 cm wide double-blade knife and placed horizontally in the measuring cell of the TA.XT plus texture analyzer (Stable Micro Systems Ltd., Godalming, UK) since the firmness of a cucumber decreases from the stem to the blossom [30]. Texture measurement was performed using a Warner Bratzler blade with a rectangular notch (Stable Micro Systems Ltd., Godalming, UK) and a blade feed rate of 1 mm/s. The maximum shear force (firmness, N/mm) and the slope of the recorded force-displacement curve from 20% to 80% of the maximal shear force (crunchiness, N/mm2) were measured using Exponent Connect software (Stable Micro Systems Ltd., Godalming, UK). The texture values were related to the diameter of the gherkin slice since the texture quality decreases with increasing gherkin size.
2.7. Sample Preparation for Measuring Pectinolytic Enzyme Activity
Samples inoculated with different fungi originating from rotten gherkins were used to determine the enzyme activity of endo-PG, exo-PG, PE, and pectin lyase. The aim was to identify typical gherkin spoilage fungi with pectinolytic potential for softening the pickled product.
2.7.1. Preparation of Inoculated Cucumber Bouillon
The fungi M. hiemalis, M. fragilis, and G. geotrichum were cultivated on PDA (for the preparation of fungal culture, see Section 2.3). A fungal-overgrown 1 cm × 1 cm PDA section was added to an autoclaved 1 L nutrient bouillon based on 860 g of pureed cucumber and 660 g 0.9% physiological saline (NaCl) and shaken (50 rpm) at 25 °C for seven days. The liquid fungal cultures were used to obtain fungal pectinolytic enzymes. A 0.5 L nutrient bouillon (430 g of cucumber and 330 mL of a 0.9% NaCl solution) without fungal inoculation was used for the calibration of the enzymatic measurement and as a control. The NaCl content of the bouillons was adjusted to 0.5 M before recovering the enzymes.
2.7.2. Sample Preparation with Ultrafiltration
Sample preparation and the preparation of all required solutions for the individual measurements of pectinolytic enzyme activities were performed according to the methods described in Scharf et al. (2022) [31]. Chemicals were purchased from Carl Roth (Carl Roth GmbH & Co.KG, Karlsruhe, Germany) and Sigma-Aldrich (Sigma-Aldrich, Corp., St. Louis, MO, USA). The enzymatic measurements were performed with the following samples: Pickles taken from fungal-inoculated re-pasteurized ready-to-sell pickle jars, fungal-inoculated cucumber bouillons, fungal-inoculated, freshly harvested, and pasteurized gherkins grown in the greenhouse (stored three months). The controls were always included in the analysis. Relevant data for sample preparation are provided in Table A1 in Appendix A.
2.8. Measuring of Pectinolytic Enzyme Activity
The preparation of all buffers, pectin substrates, sample solutions, and procedures for enzyme activity measurements and calculations were performed with minor deviations according to Scharf et al. (2022) [31]. In this section, only the minor deviations were described, and the equipment used was listed. All measurements were performed in triplicate.
2.8.1. Polygalacturonase Viscosity Assay at 30 °C
First, 200 mL of pectin-buffer solutions with pH values between 3.0 and 6.0 was prepared for the measurement of endo-PG activity. Then, 2.5 mL of the substrate solution with suitable pH was heated to 30 °C and mixed with 0.5 mL of the prepared sample. The mixture was subsequently added to the micro Ubbelohde viscometer (type 53,710/K = 0.01, SI Analytics and AVS 370 software, version 3.83.00 for calculation).
The activities were given as units per gram [u/g] of the inoculated gherkin samples.
2.8.2. Polygalacturonase Viscosity Assay in a Substrate-Solution of up to 80 °C
Due to high endo-PG activity at a test temperature of 30 °C and a pH of 5.5, further analyses were performed with varying pH values between 3.0 and 6.0 (increase in 0.5 steps) and varying substrate temperatures up to 80 °C. The aim was to simulate a possible inactivation of the enzyme during pasteurization.
2.8.3. Photometrical Assay to Measure Exo-PG Activity and Pectin Lyase at 30 °C
Based on the photometric method of Honda et al. (1982) for measuring reducing carbohydrates at 276 nm (UV-3100PC, VWR International, LLC, Radnor, PA, USA), 0.25 mL of diluted and desalted extracted gherkin samples were mixed with the buffer (0.5 mL) and the substrate (0.25 mL) [32]. Pectin lyase was measured photometrically at a wavelength of 235 nm with a tempered substrate solution (30 °C) of acetate buffer and pectin from apples. Then, 2.5 mL of this solution was mixed with 0.6 mL of the inoculated gherkin sample and measured at the above wavelength in steps of 10 s to 180 s and then after a total time of 5, 10, and 15 min.
2.8.4. Titration Assay to Measure Pectinesterase Activity at 30 °C
PE was measured titrimetrically at a temperature of 30 °C. Ten milliliters of the substrate solution were mixed with 1 mL of the gherkin sample when measurement started.
2.9. Statistical Methods to Calculate Enzymatic Activity
Statistical tests were performed using SPSS (SPSS 28.0 for Windows, SPSS Inc., Chicago, IL, USA). Mean values and standard deviations were reported. Analyses of variance (ANOVA, 28.0 SPSS 28.0 for Windows) and Tukey HSD tests for multiple comparisons were additionally performed.
3. Results
3.1. Various Fungi Isolated from Rotting Gherkins
The six different genera Fusarium, Mucor, Galactomyces, Plectophaerella, Alternaria, and Cladosporium were identified from 44 separated fungal colonies using the ITS sequence data and supported by morphological determinations. Fusarium occurred most frequently with nearly 48% of all isolates, followed by Mucor with 20.5%. The following species were identified: F. equiseti, F. oxysporum, F. solani, M. hiemalis, M. fragilis, M. circinelloides, G. geotrichum, and P. cucumerina, while isolates identified as Alternaria sp. and Cladosporium sp. could not be determined more specifically. Figure 2 shows the frequency of fungal isolates from the total number of fungal cultures analyzed.

Figure 2.
Fungal isolates from rotten gherkins. Forty-four fungal isolates obtained from rotting gherkins were analyzed by sequence data and morphological determination. The following species were identified: Fusarium equiseti, Fusarium oxysporum, Fusarium solani, Mucor hiemalis, Mucor fragilis, Mucor circinelloides, Galactomyces geotrichum, and Plectosphaerella cucumerina, while isolates identified as Alternaria sp. and Cladosporium sp. could not be determined more specifically.
3.2. Recultivability of Applied Fungi from Non-Re-Pasteurized, Ready-to-Sell Pickle Jars
Ready-to-sell pickle jars were inoculated with the identified fungal isolates to simulate fungal contamination in the jar during processing, potentially inducing product softening. These treated ready-to-sell jars were subsequently re-pasteurized except for one jar per inoculant (200 spores/mL). All non-re-pasteurized but inoculated ready-to-sell jars were stored to test the tolerance of fungal inoculants to the acidic-salty environment in the pickle jars without prior heat treatment by pasteurization. Fungal growth on PDA was detected 14 days after inoculation in the samples taken from the jars containing the inoculants G. geotrichium, M. fragilis, and M. hiemalis. At 28 days after inoculation, only samples from M. hiemalis inoculated jars showed fungal growth. No further fungal growth was noted in any of the inoculated pickle jars during the remaining sampling procedure. Fungal growth was observed in the vinegar broth and on the gherkin material. It was noticeable that fungal growth rarely occurred on the center slices of the gherkins but rather on the slices taken from the blossom and stem side. Fungal growth on the samples is shown in Figure 3.
Figure 3.
Fungal growth on samples taken from inoculated ready-to-sell pickle jars. Ready-to-sell pickle jars were inoculated with different fungi isolated from rotten gherkins to simulate fungal contamination and potentially induce softening of the pickles. Fungal growth was evident on the gherkin slices and vinegar broth placed on a nutrient medium after 14 days after inoculation in Galactomyces geotrichum (A,B), Mucor fragilis (C,D), and Mucor hiemalis (E,F). The latter grew even after 28 days after inoculation in the applied vinegar broth (G,H). The aim was to analyze the fungal tolerance to the acidic-salty milieu in the pickle jar.
3.3. Texture of Pickles from Re-Pasteurized Jars Ready for Sale, Inoculated with Various Spore Suspensions
Texture values of pickle samples from the inoculated re-pasteurized ready-to-sell jars were compared with batch-corresponding controls (also re-pasteurized) (Figure 4). The firmness of the pickles decreased compared to the corresponding control in all inoculation variants (Figure 4A). The greatest decrease in firmness of 41% was measured in samples from M. circinelloides-inoculated jars (2000 spores/mL, lot 1), followed by G. geotrichum (inoculated with 2000 spores/mL) and P. cucumerina-inoculated samples (a 32.4% firmness decrease). The lowest decrease in firmness (1.4%) compared to the control of the same batch was measured for samples inoculated with M. hiemalis (2000 spores/mL). In contrast, the crunchiness of pickles inoculated with Alternaria sp., Cladosporium sp., and F. oxysporum even increased compared to the control. The crunchiness of the other inoculation variants also decreased or was almost equal to the crunchiness values of the same batch control (Figure 4B). The greatest reduction in crunchiness compared to the corresponding control was measured in pickles inoculated with M. circinelloides (2000 spores/mL, lot 1), with a 24.1% reduction, and M. hiemalis (200 spores/mL) (21.8% reduction), followed by M. fragilis with 21.6% reduction. In summary, samples inoculated with M. circinelloides (2000 spores/mL, lot 1) showed the greatest reduction in both texture parameters. Inoculates generally affected gherkin firmness more than crunchiness. A significant decrease in firmness could be measured in samples inoculated with Alternaria sp., Cladosporium sp., F. oxysporum, G. geotrichum, M. circinelloides, M. hiemalis (200 spores/mL), and P. cucumerina. In contrast, a significant reduction in crunchiness was recorded only in gherkins inoculated with M. fragilis (2000 spores/mL), M. hiemalis (212 spores/mL), and P. cucumerina.

Figure 4.
Texture changes in gherkins due to fungal inoculation. Ready-to-sell pickle jars were inoculated with spore suspensions of the fungi Plectosphaerella cucumerina, Mucor hiemalis, Mucor fragilis, Mucor circinelloides, Galactomyces geotrichum, Fusarium oxysporum, Fusurium equiseti, Cladosporium sp., and Alternaria sp. Inoculation was performed with the final concentrations of 2000 spores/mL (dark gray) and 200 spores/mL (vertically striped) in the jar or with a fungus-covered 1 cm × 1 cm PDA section (checkered) if no spores could be obtained. Afterward, the jars were re-pasteurized, and after six months of storage, the crunchiness (N/mm2) (B) and firmness (N/mm) (A) of the gherkins were measured. Texture values of individual samples were compared with controls (medium gray) from the same batch (lot 1 and lot 2 are different batches with the same inoculant). ANOVA was performed with significant correlations at * p ≤ 0.05, ** p ≤ 0.01, *** p ≤ 0.0001. Shown are the mean values (n = 6 to 28) with standard deviation.
3.4. Fungal Inoculation of Greenhouse Gherkins
Based on the evidence of the fungi inoculated, recoverable from non-re-pasteurized, ready-to-sell pickle jars, blossoms of greenhouse-grown gherkin plants were inoculated with spores of the fungi G. geotrichum, M. hiemalis, and M. fragilis. The aim was to induce the softening of pickles by infecting the fruit as it grows. Inoculation of the blossom should enable the inoculated fungus to establish on the fruit, invade the gherkin, and affect it texturally during growth. This should simulate fungal infection during cultivation in the field.
3.4.1. Recultivability of Fungi Inoculated on Greenhouse Gherkins
Fungal growth was observed on gherkin slices and blossoms placed on PDA (Figure 5). The gherkin pieces of the stem, center, and blossom part were heterogeneously colonized, but no visual differences in fungal growth were evident. No fungal growth was detected on gherkins harvested from non-inoculated control plants, thus no transfer of sprayed inoculants to other fruits occurred. The most severe fungal growth was observed in samples of gherkins treated with a mixture of the three inoculant fungi with Mucor as the dominant fungi. Samples inoculated with G. geotrichum showed increased growth of unspecified other fungi (up to 40% of total fungal growth on PDA plate) in addition to fungal growth of G. geotrichum. Gherkins inoculated with M. hiemalis or M. fragilis showed little to no fungal growth of other species.

Figure 5.
Fungal growth on inoculated fresh gherkins. Open gherkin blossoms were sprayed with spore suspensions of the fungi Galactomyces geotrichum, Mucor hiemalis, Mucor fragilis, or a mixture of the three fungi. Gherkin slices and blossoms placed on PDA showed fungal growth corresponding to the respective inoculum.
3.4.2. Texture of Fresh and Pasteurized Inoculated Greenhouse Gherkins
The texture was measured from a total of 216 harvested greenhouse gherkins. The blossoms of the plants were previously treated with G. geotrichum, M. hiemalis, M. fragilis, or a mixture of all three fungi. Control gherkins were harvested from untreated plants. Neither the plants nor the fruits showed any phenotypic symptoms indicating a fungal infection, a decline in plant health, or a change in the quality of the gherkins due to the fungal inoculation during the entire trial period. Furthermore, 196 gherkins were pasteurized after harvest and stored for 12 weeks before texture measurements.
The texture of the remaining gherkins was determined in the unprocessed state. The firmness and crunchiness of fresh gherkins indicated no significant differences between the inoculation variants and the control. The firmness averaged 2.178 N/mm for the control, followed by M. fragilis (2.290 N/mm), G. geotrichum (2.306 N/mm), mixture-inoculated gherkins (2.358 N/mm), and finally, M. hiemalis-treated gherkins with 2.434 N/mm firmness. The average values of crunchiness also did not indicate any remarkable variance between the inoculation variants (G. geotrichum of 0.809 N/mm2, M. fragilis of 0.896 N/mm2, M. hiemalis of 0.891 N/mm2, and mixture inoculation of 0.835 N/mm2) and the control gherkins (control of 0.787 N/mm2).
No significant differences occurre” regarding the crunchiness and firmness of the stored pasteurized pickles compared to the inoculation variants and the control (Figure 6). The average texture values of the inoculated pickles differed from the control values by only approximately 1% for firmness and approximately 8% for crunchiness under G. geotrichum and M. fragilis treatments. Inoculation with M. hiemalis resulted in a 6% firmer and 2% crunchier texture concerning the control, while the variation in mixture-inoculated gherkins compared to the control was an infinitesimal 0.16% for firmness and 3% for crunchiness. The range of variation within the measurement groups is approximately the same and corresponds to the natural variation of the natural product.

Figure 6.
Texture of fresh and pasteurized inoculated greenhouse gherkins. Blossoms of gherkin plants grown in the greenhouse were sprayed with spore suspensions of Galactomyces geotrichum, Mucor hiemalis, Mucor fragilis, or a mixture of the three fungi. Texture values of fresh gherkins (A) were determined within 48 h after harvest. Most of the harvested gherkins were separately pasteurized in a salt–vinegar solution and stored for 12 weeks before crunchiness (N/mm2, dark gray) and firmness (N/mm, light gray) were measured (B). No significant texture differences occurred between the inoculation variants and the control.
3.5. Measurement of Enzymatic Activity
3.5.1. Endo-PG Activity at Different Processing Stages of Fungal-Inoculated Gherkins at Fixed pH and Temperature
Endo-PG activity was measured from inoculated, re-pasteurized, ready-to-sell pickle jars; inoculated, freshly harvested, and pasteurized (stored for 3 months) greenhouse gherkins; and inoculated cucumber bouillon. The fungi G. geotrichum, M. hiemalis, and M. fragilis were used for inoculation. Differences in the level of endo-PG activity were shown between inoculation variants. The measurements were performed at a fixed temperature of 30 °C and a pH of 5.5. The results of the inoculation trials are presented in Table 2. Based on the mean values of three replicates (from one batch), the re-pasteurized, ready-to-sell pickles exhibited low endo-PG activities of less than <0.07 u/g, regardless of the inoculated fungus, thus ranging within the lower detection limit. Similar results were obtained for inoculated pasteurized greenhouse gherkins. The endo-PG activities of inoculated, freshly harvested greenhouse gherkins were slightly higher, especially for the control sample with 0.19 ± 0.02 u/g. In contrast, the activity of endo-PG in M. hiemalis- and G. geotrichum-inoculated samples was much lower (<0.07 u/g). In contrast, a significantly higher endo-PG activity was measured in the inoculated cucumber bouillons. The cucumber broth inoculated with M. hiemalis showed an endo-PG activity of 3.57 u/g, whereas the enzyme activity in the bouillon inoculated with M. fragilis (6.37 u/g) and G. geotrichum (7.39 u/g) approximately doubled this value. However, the endo-PG activity of the control bouillon without the inoculant was at the limit of detection again.

Table 2.
Endo-Polygalacturonase activity at different processing stages of fungal-inoculated gherkins at pH 5.5 and a temperature of 30 °C. The fungi Galactomyces geotrichum, Mucor hiemalis, and Mucor fragilis were used for inoculation.
3.5.2. Endo-PG Activity Measured in Fungal-Inoculated Cucumber Bouillons at a Constant Temperature and Varying pH
Based on high endo-PG activities in inoculated cucumber bouillons, further trials with pH between 3.0 and 6.0 (increase by 0.5 increments) were performed to investigate the activities of endo-PG in a more acidic or basic range. The temperature was maintained at 30 °C. The mean values of the trials with different pH values are presented in Figure 7A. Due to the low endo-PG activities observed in the control measured at pH 5.5 (0.06 ± 0.01 u/g), no further tests were performed with it at other pH values. Enzyme measurements of cucumber bouillon inoculated with G. geotrichum indicated increasing activity beginning at pH 3.0 with 0.24 u/g and a maximum of 11.7 u/g at pH 6.0. The endo-PG activity of the bouillon inoculated with M. hiemalis was variable at pH < 4.5 with the optimum at pH 4.5 (8.57 ± 0.11 u/g) and an approximately threefold lower activity at pH 6.0 (2.84 ± 0.09 u/g). The maximum with the M. fragilis inoculant was measured at pH 4.0 with 31.11 ± 0.35 u/g. In addition, significantly higher activities were also detected at pH 3.5 (17.72 u/g), pH 4.5 (18.83 u/g), and pH 5.0 (13.03 u/g). The endo-PG activity measurements in the inoculated cucumber broth revealed that M. fragilis has the highest tissue-softening potential in the acidic milieu corresponding to the cucumber–vinegar solution.

Figure 7.
Endo-Polygalacturonase activity of fungal-inoculated gherkins. Cucumber bouillons were inoculated with the fungi Mucor hiemalis, Mucor fragilis, or Galactomyces geotrichum. All enzymatic measurements were performed in triplicate (n = 3). (A) The endo-PG activity [u/g] induced by the fungi was measured in the pH range of 3.0 to 6.0 (increase in 0.5 increments). Due to the low endo-PG activities observed in the control measured at pH 5.5, no further tests were performed with it at other pH values. The temperature was fixed at 30 °C during measurement. (B) The endo-PG activity induced by the fungi was measured in the temperature range of 30 °C to 80 °C (fixed pH at 5.5).
In addition, further trials with varying temperatures between 30 °C and 80 °C and fixed pH at 5.5 were performed to investigate the heat tolerance of the enzyme. The aim was to verify whether pasteurization can inactivate endo-PG induced by various fungi. The mean values of the temperature trials are shown in Figure 7B. Each measurement of enzyme activity was performed twice with the same extract obtained from the inoculated cucumber bouillon under identical conditions. The measurement at 30 °C required the preparation of two extracts obtained from one bouillon with the same inoculant. Due to this, larger standard deviations were measured. The enzymes are almost completely inactivated in all fungal inoculation variants at the maximum temperature of 80 °C and a heating period of three minutes. The high endo-PG activity measured at 30 °C was not detected in any of the samples above 60 °C and was highest in bouillon samples inoculated with G. geotrichum at 2.33 u/g, followed by M. hiemalis (0.5 u/g) and M. fragilis (0.18 u/g) inoculated bouillons. The enzyme activity decreased further with increasing temperature and was finally close to the detection limit in all measurements. The pasteurization of pickles occurs at a minimum of 80 °C (>3 min). Therefore, the endo-PG of the fungal inoculants used here would be expected to be inactivated during this process.
3.5.3. Exo-PG and Pectinlyase Activity at Different Processing Stages of Fungal-Inoculated Gherkins
Small amounts of exo-PG and pectin lyase were found in all samples. The measured enzyme activities were close to the detection limit. The mean values for the enzymes mentioned are listed in Table A2.
3.5.4. PE Activity at Different Processing Stages of Fungal-Inoculated Gherkins
PE activity was measured from inoculated, re-pasteurized, ready-to-sell pickle jars; inoculated, freshly harvested, and pasteurized (stored for three months) greenhouse gherkins; and inoculated cucumber bouillon. However, PE activity could only be detected in the inoculated freshly harvested greenhouse gherkins. The measured enzyme activities were below 0.72 ± 0.01 u/g, a comparable range to the control (0.70 ± 0.03 u/g).
4. Discussion
Firm and crunchy texture is a critical quality attribute in pickles, thus softening of the finished product is a deficiency associated with economic loss. Pathogenic fungi have long been hypothesized and studied as a cause of softening in processed gherkins. However, most of these studies focused on the softening of fermented or brined gherkins [6,15,22,32,33]. Texture softening also occurs in pickled heat-treated gherkins, which has been the focus of a small number of studies to date and was investigated here. The fungi detected in the present study have also been documented in other studies on cucumbers and were associated with softening of the processed product or spoilage [21,22,34,35]. These studies analyzed texture-degrading enzyme potentials of the isolated fungal species, but neither the fungi nor their enzymes were tested for acid tolerance and heat resistance, a focus of the present study. Thus, these fungi (F. equiseti, F. oxysporum, F. solani, M. hiemalis, M. fragilis, M. circinelloides, G. geotrichum, P. cucumerina, Alternaria sp., and Cladosporium sp.) have the potential to produce tissue-damaging enzymes. Various tests were carried out to determine whether individual candidates of the fungi isolated here contribute to the softening of the product. Fungal infections with potential candidates were performed at different stages of the production chain, followed by textural, microbiological, and enzymatic studies.
The re-pasteurized, ready-to-sell pickles contaminated with different spore suspensions showed that the fungi studied have texture-damaging properties and, in particular, significantly reduced the crunchiness and firmness in some cases, which is crucial for the sensory perception of the customer. Raymond et al. (1959) indicate that the fungi most commonly detected on field-grown cucumbers and during processing have the highest pectinolytic potential” [22]. Fusarium, which has often been shown to be highly abundant in cucumber [22,35] as it was in the present study, had little effect on the gherkin texture. Among the more abundant fungi, only M. circinelloides exhibited a severe reduction in textural properties, ranked immediately below G. geotrichum. Furthermore, the latter was the only fungus that measurably reduced both firmness and crunchiness compared to the control. Both G. geotrichum and Mucor spp. colonize various foods such as milk products, cereals, and fruits or inhabit soil, water, air, humans, and animals [36,37]. In citrus, mango, pear, and other fruits, post-harvest decay has already been attributed to Mucor spp. (Mucor rot) [38,39,40]. G. geotrichum, an acid-tolerant, yeast-like fungus (teleomorph of Geotrichum candidum), tolerates pH values between 3 and 11, and the optimal range is 5 to 7, thus G. geotrichum had only moderate occurrence in the cucumber jars [37]. M. hiemalis, M. fragilis, and G. geotrichum were the only fungi that could be recultured from the non-re-pasteurized jars, with M. hiemalis surviving the longest in the jar at 28 days. Acid tolerance of pH < 4 has already been demonstrated for the Fusarium species present here, yet recultivation was not possible. Fungal growth under acidic conditions has also been demonstrated for M. hiemalis. The low pH of the vinegar–salt solution in pickle jars makes them more susceptible to spoilage by fungi (and yeasts) than by bacteria [41]. In contrast, minimal amounts of endo-PG were detected in the pickle jars inoculated with G. geotrichum, M. hiemalis, and M. fragilis, even though these fungi caused a high level of texture damage or could be recultured from the acid-saline milieu. In the present study, endo-PG extracted from M. fragilis inoculated bouillon had its optimum activity below pH 4, which corresponds to the pH range of the pickling brine. M. hiemalis, with the longest recorded viability in the jar, showed fluctuating enzyme activity at pH < 4. G. geotrichum’s enzyme activity increased with increasing pH but was rather unsuitable for the pH < 4 range. Other studies have already demonstrated the tissue-damaging properties in terms of cellulose and pectin degradation of G. geotrichum and various Mucor species, some even at acidic pH [42,43]. Voldrich et al. (2009) could not measure fungal contamination or enzyme activity in the product despite severe texture changes in pasteurized cucumbers and concluded that residual fungal enzyme activity alone could be responsible for the texture change [23]. The final concentration of spores used in the pickle jars may not have been sufficient to cause texture-damaging fungal growth, so the number of spores would have to be increased. However, if a small amount of enzyme is sufficient to soften the cucumbers, a small number of spores could also be effective in causing post-harvest damage to the texture of the gherkins.
For texture breakdown of the gherkins in the jar, the fungi and their enzymes must permanently survive both the low pH of the vinegar-salt solution in the jar and processing, i.e., the high-temperature pasteurization (80 °C). Heat-resistant fungi have been recognized as pathogens that are able to spoil thermally processed fruit and fruit products. Fruits that have more contact with the soil are more susceptible to contamination by heat-resistant fungi found in soils around the world [43]. The extracted enzymes from the cucumber bouillons inoculated with M. fragilis, M. hiemalis, or G. geotrichum did not exhibit sufficient heat stability to survive pasteurization and soften cucumber texture during product storage. Yagushi et al. (2010) demonstrated a low heat resistance for Mucor spp., insufficient for surviving pasteurization [43]. In this study, only minimal amounts of enzymes from M. hiemalis survived heating to 80 °C for 3 min. The insufficient heat stability of the enzymes explains the small to moderate decrease in firmness and crunchiness of the gherkins from the inoculated, re-pasteurized ready-to-sell pickle jars, despite a sufficiently high measured endo-PG activity at pH ≤ 4 in the cucumber bouillon. However, Cho et al. (2012) indicate that PG in homogenized tissue in pickling brine is much more heat stable than PG in purified extracts in buffer solution, as was performed in this study [24]. The present study suggests that some fungal tissue degrading enzymes (endo-PG) have sufficient acid stability, but the process of softening would require fungal enzymes with concomitant thermostable properties, as previously proposed by Voldrich et al. (2009) [23]. In studies on the softening of various canned fruits, some endo-PGs from Mucoraceous spp. were occasionally detected with heat tolerance up to a temperature of 120 °C for an exposure time of 10 min [25]. Nevertheless, evidence for thermostable fungi and their enzymes has not yet been found in pickled and pasteurized gherkins. Softening may be thought to be caused by only a few less common species or species we could not cultivate on PDA. Another possibility might be that the fungi penetrate deeper into the gherkin through injury to the epidermis or use the injury as a niche to survive pasteurization. Temperatures within the gherkin are approximately 3 °C lower during pasteurization, making the survival of the fungi or their enzymes more likely [19]. Native enzymes can also contribute to texture softening, especially if the temperature inside the cucumber does not increase as much during processing. In other studies, native PG activity could be detected at 90 °C with an exposure time of 4.4 min, while the inactivation of PG of different isoforms of tomato fruit occurred between 57 and 90 °C and was even detected at 79 °C [24,44]. The immature gherkins to be processed generally contain low amounts of texture-damaging enzymes (enzymes increase during ripening), which would be further reduced by pasteurization. The light enzyme activities measured in fresh gherkins could no longer be detected in the finished product after pasteurization. The lack of evidence for enzyme activity also excluded native enzymes, as there was no distinction between native and fungal enzymes.
The results show that post-harvest contamination of the product by the tested fungi alone seems unlikely to cause enzymatic softening, as both the fungi and the pectinolytic enzymes were inactivated by heat and acid. Moreover, the period between harvest and processing of the gherkins appears insufficient to enable the fungus to a tissue-damaging infection or establishment on the fruit.
Therefore, further research was conducted to determine whether pre-harvest contamination of the gherkins with fungi is more likely to induce softening. Open blossoms were inoculated with M. hiemalis, M. fragilis, G. geotrichum, or a mix of all three fungi, allowing the fungi to establish on the emerging gherkin and possibly enter the fruit through the blossom. All fungi could be detected on fresh fruits and blossoms, whereas G. geotrichum was most strongly displaced by other fungi. Etchells et al. (1958) and Raymond et al. (1959) suspected that large quantities of fungi with pectolytic properties could enter the jar via adhering blossom residues [21,22]. In the present study, severe fungal growth was also observed on the blossoms spread on the nutrient medium. Therefore, all inoculated harvested gherkins were pasteurized with the blossom, if still present, to include this fungal source of contamination. Even with the pre-harvested fungal-contaminated gherkins, neither a change in texture nor a sufficiently high enzymatic activity was found either in fresh or pasteurized gherkins.
The results suggest that the pectinolytic potential of the fungi used in the present study may not be sufficient to soften pickles. In addition, this study demonstrated that pre-harvest fungal contamination without other influences, such as injury to the epidermis by insects or harvesting methods, does not cause softening. The hypothesis of thermophilic fungi and enzymes as the cause of softening has not yet been rejected. The residual enzyme activity of fungi was not sufficient to significantly affect gherkin texture in our study. Kersten et al. (2021) have already shown that pre-harvest infection with plant viruses could soften cucumbers in the jar, even though the fruits in their raw state showed no sensory texture changes apart from external conspicuousness [20]. The source of softening observed in pasteurized gherkins could therefore have a non-fungal origin.
Our study elucidates that conventionally occurring fungi due to post- or pre-harvest contamination on the gherkin surface, the blossoms, or the product without further influences do not lead to softening as a causal agent but have to be considered as contributing factors. Fungi do have an impact as a cause of softening of pasteurized gherkins due to their pectinolytic potential. The process parameters appear to be optimal for sufficient enzymatic and microbial inhibition. We conclude that a cascade of pre- and post-harvest influences of phytopathogenic fungi and other biotic or even abiotic factors would be a conceivable cause of softening of pasteurized gherkins. Viruses, as one of these other biotic factors, have been recently studied, and remarkably, viruses could be confirmed as causal agents [20].
Supplementary Materials
The following supporting information can be downloaded at: https://www.mdpi.com/article/10.3390/horticulturae9030312/s1, The sequences of all isolated fungal samples can be found in the Supplementary Materials S1: Sequences of extracted DNA of the pure fungal isolates originating from rotten gherkins.
Author Contributions
Conceptualization, A.-K.K., S.S., P.M. and S.S.; methodology, A.-K.K., S.S., P.M. and A.J.; formal analysis, A.-K.K. and S.S.; investigation, A.-K.K., S.S. and A.J.; resources, C.B. and P.M.; data curation, A.-K.K.; writing—original draft preparation, A.-K.K.; writing—review and editing, A.-K.K. and S.S.; visualization, A.-K.K.; supervision, C.B.; project administration, P.M. and P.L.; funding acquisition, P.L. and P.M. All authors have read and agreed to the published version of the manuscript.
Funding
This research was funded by the European agricultural fund for rural development (EAFRD) (project number 204016000007/80168354).
Data Availability Statement
The data presented in this study are available upon request from the corresponding author.
Acknowledgments
We thank Nunhems Germany GmbH for providing cucumber seeds of the cultivar ‘Platina’. We thank Ulrike Klauß, Luisa Kiesecker, and Petra Lange for their methodical support.
Conflicts of Interest
The authors declare no conflict of interest.
Appendix A

Table A1.
Relevant data for sample preparation for enzymatic measurement. Samples of various origins (pickles taken from fungal-inoculated, re-pasteurized, ready-to-sell pickle jars, fungal-inoculated cucumber bouillons, fungal-inoculated, freshly harvested, and pasteurized (stored for three months) gherkins grown in the greenhouse were used to measure pectinolytic enzyme activity based on fungal inoculation. The fungi Mucor hiemalis, Mucor fragilis, and Galactomyces geotrichum or a mix of the previously listed fungi were inoculated. Measurements were based on one extract with three measurements out of one batch.
Table A1.
Relevant data for sample preparation for enzymatic measurement. Samples of various origins (pickles taken from fungal-inoculated, re-pasteurized, ready-to-sell pickle jars, fungal-inoculated cucumber bouillons, fungal-inoculated, freshly harvested, and pasteurized (stored for three months) gherkins grown in the greenhouse were used to measure pectinolytic enzyme activity based on fungal inoculation. The fungi Mucor hiemalis, Mucor fragilis, and Galactomyces geotrichum or a mix of the previously listed fungi were inoculated. Measurements were based on one extract with three measurements out of one batch.
| Amounts of Inoculants | Prepared Enzyme Extracts | ||||
|---|---|---|---|---|---|
| Inoculants | Spores Per mL in the Jar | Raw Weight Sample [g] | Volume after Ultrafiltration [mL] | Concentration Factor | |
| Re-pasteurized ready-to-sell pickles | M. hiemalis | 200 | 100.79 | 31.0 | 3.25 |
| M. fragilis | 2000 | 100.89 | 31.0 | 3.25 | |
| G. geotrichum | 2000 | 100.69 | 31.0 | 3.25 | |
| cucumber bouillon | Control | 114.00 | 27.0 | 4.22 | |
| M. hiemalis | 114.00 | 25.0 | 4.56 | ||
| M. fragilis | 114.00 | 26.0 | 4.38 | ||
| G. geotrichum | 114.00 | 27.0 | 4.22 | ||
| Inoculated fresh greenhouse gherkins | Control | 100.17 | 29.5 | 3.40 | |
| M. hiemalis | 100.35 | 19.5 | 5.15 | ||
| M. fragilis | 97.83 | 26.0 | 3.76 | ||
| G. geotrichum | 100.24 | 27.5 | 3.65 | ||
| Mix | 100.90 | 29.0 | 3.48 | ||
| Pasteurized greenhouse gherkins | Control | 100.83 | 24.5 | 4.12 | |
| M. hiemalis | 100.07 | 17.0 | 5.89 | ||
| M. fragilis | 94.21 | 25.0 | 3.77 | ||
| G. geotrichum | 100.64 | 22.5 | 4.47 | ||
| Mix | 100.50 | 24.0 | 4.19 | ||

Table A2.
Exo-Polygalacturonase and pectinlyase activity at different processing stages of fungal-inoculated gherkins at pH 5.5 and a temperature at 30 °C. The fungi Galactomyces geotrichum, Mucor hiemalis, and Mucor fragilis were used for inoculation.
Table A2.
Exo-Polygalacturonase and pectinlyase activity at different processing stages of fungal-inoculated gherkins at pH 5.5 and a temperature at 30 °C. The fungi Galactomyces geotrichum, Mucor hiemalis, and Mucor fragilis were used for inoculation.
| Exo-PG Activity | Pectinlyase | ||
| Treatment | Inoculants | Activity at 30 °C [u/g] | Activity at 30 °C [u/g] |
| Cucumber bouillon | Control | - | 2.0 × 10−3 |
| M. hiemalis | 7.9 × 10−4 | - | |
| M. fragilis | 7.5 × 10−4 | 4.0 × 10−3 | |
| G. geotrichum | 4.4 × 10−4 | 1.0 × 10−2 | |
| Fresh, harvested greenhouse gherkins | Control | 9.0 × 10−4 | 1.1 × 10−2 |
| M. hiemalis | 4.3 × 10−4 | 5.0 × 10−3 | |
| M. fragilis | 3.8 × 10−4 | 1.0 × 10−2 | |
| G. geotrichum | 3.5 × 10−4 | 3.0 × 10−3 | |
| Mix | 4.8 × 10−4 | 7.0 × 10−3 | |
| Pasteurized greenhouse gherkins (3 months storage) | Control | - | 1.0 × 10−2 |
| M. hiemalis | - | 1.0 × 10−2 | |
| M. fragilis | - | 8.0 × 10−3 | |
| G. geotrichum | - | 1.2 × 10−2 | |
| Mix | - | 1.3 × 10−2 | |
| Re-pasteurizedready-to-sell pickles (6 months storage) | M. hiemalis | - | 5.0 × 10−3 |
| M. fragilis | - | 3.0 × 10−3 | |
| G. geotrichum | - | 3.0 × 10−3 |
References
- Breene, W.M.; Chou, H.-E. Texture profile analysis of cucumbers. J. Food Sci. 1972, 37, 113–117. [Google Scholar] [CrossRef]
- De Matos, A.D.; Marangon, M.; Magli, M.; Cianciabella, M.; Predieri, S.; Curioni, A.; Vincenzi, S. Sensory characterization of cucumbers pickled with verjuice as novel acidifying agent. Food Chem. 2019, 286, 78–86. [Google Scholar] [CrossRef]
- Sahoo, M.; Prakash, J. Formulation and standardization of dill based gherkin pickles: A study on physico-chemical and sensory attributes. Indian J. Nutr. Diet. 2017, 54, 387–402. [Google Scholar] [CrossRef]
- Hodges, D.M.; Toivonen, P.M. Quality of fresh-cut fruits and vegetables as affected by exposure to abiotic stress. Postharvest Biol. Technol. 2008, 48, 155–162. [Google Scholar] [CrossRef]
- Navazio, J.P.; Staub, J.E. Effects of soil moisture, cultivar, and postharvest handling on pillowy fruit disorder in cucumber. J. Am. Soc. Hortic. Sci. 1994, 119, 1234–1242. [Google Scholar] [CrossRef]
- Demain, A.L.; Phaff, H. Cucumber curing, softening of cucumbers during curing. J. Agric. Food Chem. 1957, 5, 60–64. [Google Scholar] [CrossRef]
- Pitrat, M.; Chauvet, M.; Foury, C. Diversity, history and production of cultivated cucurbits. In Proceedings of the I International Symposium on Cucurbits 492, Adana, Turkey, 20–23 May 1997; pp. 21–28. [Google Scholar]
- Sebastian, P.; Schaefer, H.; Telford, I.R.; Renner, S.S. Cucumber (Cucumis sativus) and melon (C. melo) have numerous wild relatives in Asia and Australia, and the sister species of melon is from Australia. Proc. Natl. Acad. Sci. USA 2010, 107, 14269–14273. [Google Scholar] [CrossRef]
- Tatlioglu, T. Cucumber—Cucumis sativus L. In Genetic Improvement of Vegetable Crops; Kalloo, G., Bergh, B., Eds.; Pergamon Press Ltd.: Oxford, UK, 1993. [Google Scholar]
- Reeve, R. Relationships of histological structure to texture of fresh and processed fruits and vegetables. J. Texture Stud. 1970, 1, 247–284. [Google Scholar] [CrossRef]
- Sajnin, C.; Gamba, G.; Gerschenson, L.N.; Rojas, A.M. Textural, histological and biochemical changes in cucumber (Cucumis sativus L.) due to immersion and variations in turgor pressure. J. Sci. Food Agric. 2003, 83, 731–740. [Google Scholar] [CrossRef]
- Voragen, A.G.; Coenen, G.-J.; Verhoef, R.P.; Schols, H.A. Pectin, a versatile polysaccharide present in plant cell walls. Struct. Chem. 2009, 20, 263–275. [Google Scholar] [CrossRef]
- Bell, T.A.; Etchells, J.L.; Jones, I.D. Pectinesterase in the cucumber. Arch. Biochem. Biophys. 1951, 31, 431–441. [Google Scholar] [CrossRef] [PubMed]
- Yadav, S.; Yadav, P.K.; Yadav, D.; Yadav, K.D.S. Pectin lyase: A review. Process Biochem. 2009, 44, 1–10. [Google Scholar] [CrossRef]
- Bell, T.; Turney, L.; Etchells, J. Influence of different organic acids on the firmness of fresh-pack pickles. J. Food Sci. 1972, 37, 446–449. [Google Scholar] [CrossRef]
- Bell, T.A.; Etchells, J.L. Influence of Salt (NaCl) on Pectinolytic Softening of Cucumbersa. J. Food Sci. 1961, 26, 84–90. [Google Scholar] [CrossRef]
- McFeeters, R.; Fleming, H. Effect of calcium ions on the thermodynamics of cucumber tissue softening. J. Food Sci. 1990, 55, 446–449. [Google Scholar] [CrossRef]
- McFeeters, R.; Fleming, H. pH effect on calcium inhibition of softening of cucumber mesocarp tissue. J. Food Sci. 1991, 56, 730–732. [Google Scholar] [CrossRef]
- Sistrunk, W.; Kozup, J. Influence of processing methodology on quality of cucumber pickles. J. Food Sci. 1982, 47, 949–953. [Google Scholar] [CrossRef]
- Kersten, A.-K.; Scharf, S.; Bandte, M.; Martin, P.; Meurer, P.; Lentzsch, P.; Büttner, C. Softening of Processed Plant Virus Infected Cucumis sativus L. Fruits. Agronomy 2021, 11, 1451. [Google Scholar] [CrossRef]
- Etchells, J.; Bell, T.; Monroe, R.; Masley, P.; Demain, A. Populations and softening enzyme activity of filamentous fungi on flowers, ovaries, and fruit of pickling cucumbers. Appl. Microbiol. 1958, 6, 427–440. [Google Scholar] [CrossRef]
- Raymond, F.; Etchells, J.; Bell, T.; Masley, P. Filamentous fungi from blossoms, ovaries, and fruit of pickling cucumbers. Mycologia 1959, 51, 492–511. [Google Scholar] [CrossRef]
- Voldřich, M.; Horsáková, I.; Čeřovský, M.; Čížková, H.; Opatová, H. Factors affecting the softening of pickled pasteurised cucumbers. Czech J. Food Sci. 2009, 27, S314. [Google Scholar] [CrossRef]
- Cho, M.J.; Buescher, R.W. Potential role of native pickling cucumber polygalacturonase in softening of fresh pack pickles. J. Food Sci. 2012, 77, C443–C447. [Google Scholar] [CrossRef] [PubMed]
- Harris, J.E.; Dennis, C. Heat stability of endo-polygalacturonases of Mucoraceous spoilage fungi in relation to canned fruits. J. Sci. Food Agric. 1980, 31, 1164–1172. [Google Scholar] [CrossRef]
- Duvetter, T.; Sila, D.; Van Buggenhout, S.; Jolie, R.; Van Loey, A.; Hendrickx, M. Pectins in processed fruit and vegetables: Part I—Stability and catalytic activity of pectinases. Compr. Rev. Food Sci. Food Saf. 2009, 8, 75–85. [Google Scholar] [CrossRef]
- Abarenkov, K.; Nilsson, R.H.; Larsson, K.-H.; Alexander, I.J.; Eberhardt, U.; Erland, S.; Høiland, K.; Kjøller, R.; Larsson, E.; Pennanen, T. The UNITE database for molecular identification of fungi–recent updates and future perspectives. New Phytol. 2010, 186, 281–285. [Google Scholar] [CrossRef]
- Tedersoo, L.; Nilsson, R.H.; Abarenkov, K.; Jairus, T.; Sadam, A.; Saar, I.; Bahram, M.; Bechem, E.; Chuyong, G.; Kõljalg, U. 454 Pyrosequencing and Sanger sequencing of tropical mycorrhizal fungi provide similar results but reveal substantial methodological biases. New Phytol. 2010, 188, 291–301. [Google Scholar] [CrossRef]
- Nirenberg, H. Untersuchungen über die morphologische und biologische Differenzierung in der Fusarium-Sektion Liseola. Mitt. Biol. Bundesanst. Land Forstwirtsch. Berlin-Dahlem. 1976, 169, 1–17. [Google Scholar]
- Thompson, R.; Fleming, H.; Hamann, D.; Monroe, R. Method for determination offirmness in cucumber slices 1. J. Texture Stud. 1982, 13, 311–324. [Google Scholar] [CrossRef]
- Scharf, S.; Kersten, A.K.; Lentzsch, P.; Meurer, P. Analysis of pectolytic enzymes and Alternaria spp. in fresh dill, mustard seeds, onions, and vinegar, and their influence on the softening of pickled cucumbers. J. Food Sci. 2022, 87, 808–818. [Google Scholar] [CrossRef]
- Thompson, R.; Fleming, H.; Monroe, R. Effects of storage conditions on firmness of brined cucumbers. J. Food Sci. 1979, 44, 843–846. [Google Scholar] [CrossRef]
- Yoo, K.M.; Hwang, I.K.; Eog, G., Jr.; Moon, B. Effects of salts and preheating temperature of brine on the texture of pickled cucumbers. J. Food Sci. 2006, 71, C97–C101. [Google Scholar] [CrossRef]
- Ziedan, E.S.H.; Khattab, A.E.-N.A.E.-H.; Sahab, A.F. New fungi causing postharvest spoilage of cucumber fruits and their molecular characterization in Egypt. J. Plant Prot. Res. 2018, 58, 362–371. [Google Scholar]
- Abdel-Sater, M.; Hussein, N.A.; Fetyan, N.A.; Gad, S.M. Biodiversity of mycobiota associated with some rotted vegetables with special reference to their celluloytic and pectinolytic abilities. J. Basic Appl. Mycol. Egypt 2016, 7, 1–8. [Google Scholar]
- Eliskases-Lechner, F.; Guéguen, M.; Panoff, J.M. Yeasts and Molds|Geotrichum candidum; Academic Press: Cambridge, MA, USA, 2011; pp. 765–771. [Google Scholar]
- Grygier, A.; Myszka, K.; Rudzińska, M. Galactomyces geotrichum-moulds from dairy products with high biotechnological potential. Acta Sci. Pol. Technol. Aliment. 2017, 16, 5–16. [Google Scholar] [CrossRef] [PubMed]
- Bill, M.; Chidamba, L.; Gokul, J.K.; Korsten, L. Mango endophyte and epiphyte microbiome composition during fruit development and post-harvest stages. Horticulturae 2021, 7, 495. [Google Scholar] [CrossRef]
- Saito, S.; Michailides, T.; Xiao, C. Mucor rot—An emerging postharvest disease of mandarin fruit caused by Mucor piriformis and other Mucor spp. In california. Plant Dis. 2016, 100, 1054–1063. [Google Scholar] [CrossRef] [PubMed]
- Abdullah, Q.; Mahmoud, A.; Al-Harethi, A. Isolation and identification of fungal post-harvest rot of some fruits in Yemen. PSM Microbiol. 2016, 1, 36–44. [Google Scholar]
- Zhao, P.; Ndayambaje, J.P.; Liu, X.; Xia, X. Microbial spoilage of fruits: A review on causes and prevention methods. Food Rev. Int. 2022, 38, 225–246. [Google Scholar] [CrossRef]
- Varnaitė, R.; Paškevičius, A.; Raudonienė, V. Cellulose degradation in rye straw by micromycetes and their complexes. Ekologija 2008, 54, 29–31. [Google Scholar] [CrossRef]
- Thakur, A.; Pahwa, R.; Singh, S.; Gupta, R. Production, purification, and characterization of polygalacturonase from Mucor circinelloides ITCC 6025. Enzym. Res. 2010, 2010. [Google Scholar] [CrossRef]
- Meurer, P.; Gierschner, K. Occurrence and effect of indigenous and eventual microbial enzymes in lactic acid fermented vegetables. Acta Aliment. 1992, 21, 171–188. [Google Scholar]
Disclaimer/Publisher’s Note: The statements, opinions and data contained in all publications are solely those of the individual author(s) and contributor(s) and not of MDPI and/or the editor(s). MDPI and/or the editor(s) disclaim responsibility for any injury to people or property resulting from any ideas, methods, instructions or products referred to in the content. |
© 2023 by the authors. Licensee MDPI, Basel, Switzerland. This article is an open access article distributed under the terms and conditions of the Creative Commons Attribution (CC BY) license (https://creativecommons.org/licenses/by/4.0/).